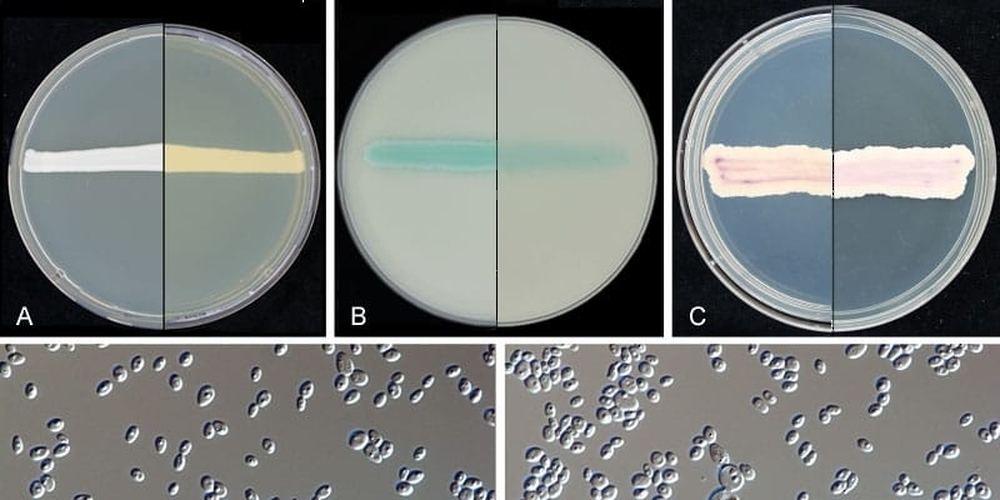
No Image

Muscat: Represented by the Natural and Medical Sciences Research Centre (NMR), the University of Nizwa has developed a new antifungal formula that proved efficient in eliminating Candida Auris infection, after two years of study.
The accomplishment was made in cooperation with a number of international universities and medical research centres in the United States, Europe and Brazil.
The discovery was lauded by international scientists, who considered it as a breakthrough in tackling the problem of antibiotics that pose a great challenge of concern to the whole world.
Dr Abdullah Mohammed al Hatmi, Assistant Professor at the NMR, in-charge of the microbiology laboratory at the Centre, said that the study conducted by the NMR is the first of its kind in addressing Candida Auris with such intensity. The study is based on assessing the activity of two antibiotic formulas of nikkomycin Z (nikZ) and diphenyl diselenide (PhSe2) used against the antibiotic resistant fungus, Dr Abdullah added.
The study was prompted by an observed rise in rates of Candida Auris infection cases over the past 10 years in many countries, including Oman, said Dr Abdullah. Besides keenness to tackle the problem here, the NMR’s study was also in response to international calls to address the global issue, he added.
Dr Abdullah explained that the newly discovered antibiotics, tested at nikZ labs, proved effective (during laboratory experiments) against Candida Auris, hitherto resistant to antibiotics.
The forthcoming few years will see further experiments that will prove whether or not the newly discovered antibiotics could be used in the production of medical drugs of use to human beings.
Dr Abdullah Al Hatmi was among the scientists who shared experiments in developing this type of antibiotics, and he authored a number of scholarly articles published in Journal of Fungi.
Oman Observer is now on the WhatsApp channel. Click here